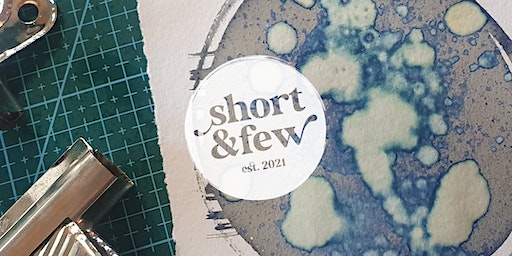
Experimental Cyanotypes | Short & Few Creative Workshops

Recent Searches
Popular Attractions
Shanghai
Jiangsu-Zhejiang-Shanghai Area,China,Eastern Asia
Da Nang
Vietnam
Arts Events in Ilkley 2024: Dates, Itinerary & Tickets Price(November Updated)
Are you interested in Tropical Palm Tree Paint Night?
245 people have participated in this
poll
Yes
No




50%



50%
Location
Event Status
Popularity
Start Time

Collage Club - Evening Arts Club | Short & Few Creative Workshops
Collage Club - Evening Arts Club is an extraordinary arts event held in the vibrant city of Ilkley. This exclusive club takes place at the renowned Short & Few Creative Workshops, located in Mayfield Avenue, Ilkley, LS29 8LF. Immerse yourself in a captivating evening of creativity, where talented artists and art enthusiasts come together to celebrate the beauty of collages. The event will take place on January 3rd, 2024, ensuring a delightful start to the new year. To add to the excitement, there is no fixed ticket price for this unique experience. Instead, Collage Club - Evening Arts Club operates on a donation basis, allowing attendees to contribute what they feel is appropriate and fair. So, mark your calendars and get ready to be enthralled by the mesmerizing world of collages. This is an opportunity not to be missed for anyone with a keen eye for art and a desire to delve into the realm of creativity. Join in the revelry and embrace the magic of Collage Club - Evening Arts Club.

Weaving is Healing Two-day workshop Sunshine Coast January 2024 | 324 Wilson Rd
Are you seeking a creative outlet to express your emotions and find solace in a world that can sometimes feel chaotic? Look no further than the Weaving is Healing Two-day workshop Sunshine Coast January 2024. This transformative arts event is set to take place in the serene city of Ilkley at the renowned venue, 324 Wilson Rd. From January 13th to January 14th, immerse yourself in the therapeutic power of weaving, as skilled instructors guide you through the intricate process of creating beautiful tapestries. Take a break from the hustle and bustle of everyday life and allow yourself to be enveloped in the calming rhythm of the loom. Whether you're a seasoned weaver or a complete beginner, this workshop offers a safe and inclusive space for all levels of experience. Tickets for this exclusive event range from $54.26 to $234.26, ensuring accessibility for all who yearn for the healing properties of art. Don't miss out on this rare opportunity to reconnect with your inner self and discover the profound connections between creativity and well-being. Mark your calendars and join us at the Weaving is Healing Two-day workshop Sunshine Coast January 2024.

The Return of The Chuck: Charlie Chuck plus supporting artistes | The Hollygarth Club
Get ready for a night of laughter as comedy legend Charlie Chuck makes a rare appearance at Moor Laughs Comedy Club at the Hollygarth in Ilkley. This renowned performer, known for his surreal and manic style, started his career as a drummer before transitioning to stand-up comedy. With his unique Charlie Chuck character act, he captured the hearts of audiences around the world. As a cast member on the BBC Two TV series The Smell of Reeves and Mortimer, he delighted viewers with his hilarious antics. Now, as the Life President of Moor Laughs Comedy Club, he is thrilled to return for an encore performance at the Hollygarth. Joining Charlie Chuck on stage will be a strong supporting undercard of talented comics. The evening will be hosted by the experienced 'master of ceremonies' Robson Stroud, mentored by none other than Charlie Chuck himself. Moor Laughs Comedy Club is dedicated to bringing laughter to the Yorkshire Moors, consistently booking nationally-acclaimed headliners and providing a full lineup of top-quality comedians. With a fully-stocked bar offering competitively-priced drinks and snacks, you can enjoy a great night out. Don't miss this incredible event on January 27, 2024, at The Hollygarth Club in Ilkley. Tickets are priced at £24.54.

Weaving is Healing Sunshine Coast February 2024 | Weavery HQ
Weaving is Healing Sunshine Coast February 2024 is an eagerly anticipated arts event that is set to take place in the picturesque city of Ilkley. The venue for this unique gathering is none other than the esteemed Weavery HQ, located at 324 Wilson Road, Ilkley, QLD 4554. On the 3rd of February 2024, attendees will have the opportunity to immerse themselves in the therapeutic art of weaving while basking in the serene ambiance of the Sunshine Coast. The event promises to be a haven for those seeking solace and healing through the creative process of weaving. With a ticket price range of $54.26 to $128.37, this event caters to individuals from all walks of life, ensuring accessibility for all who wish to partake in this enlightening experience. Weaving is Healing Sunshine Coast February 2024 is a must-attend occasion for anyone looking to explore the transformative power of art and connect with like-minded individuals in an idyllic setting. Don't miss out on this extraordinary opportunity to embark on a journey of self-discovery and healing through the beautiful craft of weaving.

Baroque Music Spectacular | All Saints' Parish Church, Ilkley
Experience an unforgettable evening of extravagant Baroque melodies at the Baroque Music Spectacular event in Ilkley. This mesmerizing concert will transport attendees to a world of musical splendor, offering a captivating celebration of the arrival of Spring.
Held at the distinguished All Saints' Parish Church, located at 4 Church Street, Ilkley, LS29 9DS, this enchanting performance will take place on February 18, 2024. Immerse yourself in the rich and ornate sounds of Baroque music, expertly performed by talented musicians.
Baroque Music Spectacular promises an awe-inspiring showcase of the genre's signature melodies, filled with intricate harmonies and ornamental embellishments. From the grandeur of Bach to the emotional depth of Handel, this event is a must-see for any music enthusiast.
Tickets for this remarkable evening are priced between £9.38 and £22.38, offering a range of options to suit every budget. Don't miss the opportunity to be part of this extraordinary occasion, where the beauty of Baroque music will come to life in all its glory.
Join us at Baroque Music Spectacular in Ilkley and be captivated by the magnificent melodies that have stood the test of time. Fall under the spell of Baroque and embrace the magic of this musical journey. Secure your tickets today to ensure your place at this extraordinary event.

Comedy Night at the Hollygarth Club, Ilkley. Mystery headliner | The Hollygarth Club
Comedy Night at the Hollygarth Club in Ilkley presents a thrilling evening of laughter with a mystery headliner. This touring comic has garnered extensive TV credits, ensuring a night filled with top-notch entertainment. Hosted at the prestigious Hollygarth Club located in Leeds Road, Ilkley, this event promises to be an unforgettable experience for comedy enthusiasts. The show will take place on February 25, 2024, providing ample time for attendees to secure their tickets. With prices ranging from £11.55 to £15.34, this Comedy Night is both affordable and an excellent value for the quality of talent on display. Don't miss out on the opportunity to enjoy an exceptional night of comedy at the Hollygarth Club in Ilkley. Secure your tickets now and get ready to laugh until your sides ache.

Comedy Night at the Hollygarth, Ilkley. Andrew Lawrence + supporting comics | The Hollygarth Club
Get ready for a night of laughter and entertainment at the prestigious Hollygarth Club in Ilkley. On February 25, 2024, the highly acclaimed Andrew Lawrence, an award-winning comedian, will take the stage. Known for his remarkable talent, Andrew Lawrence has gained national recognition and has been touring the country, captivating audiences everywhere. With an impressive resume that includes numerous TV credits, this exceptional performer is sure to deliver a memorable and side-splitting performance.
Adding to the excitement of the evening, this Comedy Night at the Hollygarth Club will also feature a lineup of talented supporting comics. Prepare to be thoroughly entertained by a diverse range of comedic styles and personalities, making it an event not to be missed.
Mark your calendars and secure your tickets now for this unforgettable night of laughter. With ticket prices ranging from £11.55 to £15.34, this Comedy Night promises to be a fantastic value for an evening of top-notch comedy. Join comedy enthusiasts and aficionados from Ilkley and beyond as they gather at The Hollygarth Club for an evening of laughter, wit, and pure comedic genius. Make sure to be there and indulge in an unforgettable comedy experience.

Collage Club - Evening Arts Club | Short & Few Creative Workshops
Welcome to Collage Club - Evening Arts Club, an exciting arts event taking place in the vibrant city of Ilkley. Held at the charming Short & Few Creative Workshops venue, located on Mayfield Avenue, Ilkley, LS29 8LF, this event promises to be an unforgettable evening for art enthusiasts. Taking place on March 6, 2024, Collage Club - Evening Arts Club offers a unique opportunity to immerse yourself in the world of collage art. With a donation-based ticket price, this event is accessible to all, ensuring that everyone can experience the magic of art. Whether you're a seasoned artist or just starting to explore your creative side, this evening of artistic expression is not to be missed. From cutting and pasting to creating visually stunning compositions, Collage Club - Evening Arts Club will inspire and captivate attendees. So mark your calendars, gather your friends, and join in on the artistic journey at Collage Club - Evening Arts Club in Ilkley.

TALK: Dudley Edwards | Ilkley Manor House
Join the captivating TALK: Dudley Edwards, a mesmerizing arts event taking place in the picturesque city of Ilkley. Set amidst the historic Ilkley Manor House, nestled in the charming Castle Yard, this thought-provoking talk is not to be missed. Mark your calendars for the 15th of March 2024, when the doors will open to a world of intellectual stimulation. Dudley Edwards, a renowned figure in the arts community, will grace the stage with his insightful words and profound wisdom. With a ticket price of just £11.55, this event offers a unique opportunity to immerse oneself in the depths of artistic expression. From captivating storytelling to thought-provoking discussions, TALK: Dudley Edwards promises an evening filled with intellectual delight. Let your curiosity guide you as you navigate the captivating journey that awaits. Embrace the chance to expand your horizons, as the eloquent words of Dudley Edwards transport you to a realm of profound introspection. Don't miss your chance to be part of this unforgettable experience. Book your tickets now and embark on an artistic odyssey that will leave you inspired, enlightened, and hungry for more.

Spring Adventures with the Airedale Symphony Orchestra | King’s Hall & Winter Gardens
Spring Adventures with the Airedale Symphony Orchestra presents an opportunity to immerse oneself in the enchanting melodies performed by the local orchestra. On Sunday, March 17, 2024, at 7.30pm, the mesmerizing sounds will fill the King's Hall, Ilkley. The programme for this captivating evening features a range of orchestral masterpieces, including Rossini's beloved William Tell Overture, the captivating Killer on the Road composed by Philippa Jennings, who is also a talented cellist in the orchestra, and the fiery Conga del Fuego Nuevo by Arturo Márquez. The performance reaches its pinnacle with Dvorak's timeless New World Symphony. This event promises to be an unforgettable experience.
Tickets for Spring Adventures with the Airedale Symphony Orchestra can be purchased conveniently in three ways. Online booking is available, or tickets can be obtained from Ilkley Tourist Information. For those who prefer to make their purchase on the day, tickets will also be available at the door. The ticket prices are as follows: adults £13, concessions £12, under 18s, full-time students, and unwaged individuals can enjoy the extraordinary performance for £6, and children under 11 are admitted free of charge.
Don't miss this exceptional event in Ilkley, where the Airedale Symphony Orchestra will showcase their talent. Come and be captivated by the harmonious melodies and the skillful performance of this renowned orchestra. Book your tickets now for Spring Adventures with the Airedale Symphony Orchestra, an evening of musical excellence that promises to leave a lasting impression.

Moor Laughs March Madness! Bobby Mair + supporting comedians | The Hollygarth Club
Don't miss out on the uproarious comedy extravaganza, Moor Laughs March Madness! Experience a night filled with uncontrollable laughter as the side-splitting Bobby Mair takes the stage alongside a stellar lineup of supporting comedians at The Hollygarth Club in Ilkley. This live event guarantees an evening of riotous entertainment, brimming with unforgettable performances and gut-busting jokes. Bobby Mair, renowned for his comedic brilliance, is currently the host of ITV2's 'Killer Camp' and has appeared on popular shows such as 'Feel Good' on Netflix, 'Stand Up Sketch Show' on ITV2, 'Roast Battle' on Comedy Central, 'Guessable' on Comedy Central, '8 Out of 10 Cat's' on Channel 4, and many more. Described by Jimmy Carr as a "brilliant stand up" and hailed by The Guardian as a "bona fide tour de force," Mair's comedic prowess is unrivaled. So mark your calendars for March 24, 2024, and get ready for an evening of non-stop laughter that will leave your funny bone thoroughly tickled. Secure your tickets now for this unmissable comedy event at the unbelievable price of £15. Join the excitement at Moor Laughs March Madness and prepare for an unforgettable night of comedy madness!

Collage Club - Evening Arts Club | Short & Few Creative Workshops
Discover the vibrant world of arts at Collage Club - Evening Arts Club in Ilkley. Located at Short & Few Creative Workshops on Mayfield Avenue, Collage Club offers a unique artistic experience on April 3, 2024. Immerse yourself in a night of creativity and inspiration as you explore the art of collage-making. With a nominal donation as the ticket price, attendees can unleash their inner artist and create stunning collages in a welcoming and supportive atmosphere. Whether you are a seasoned artist or a beginner, Collage Club welcomes all art enthusiasts to come together and express themselves through this engaging medium. Don't miss this opportunity to connect with fellow art lovers and let your creativity flow at Collage Club - Evening Arts Club. Join this artistic journey and be part of a memorable evening filled with imagination and self-expression.

Intro to Bookmaking | Short & Few Creative Workshops
Join the "Intro to Bookmaking" workshop in Ilkley at Short & Few Creative Workshops on Mayfield Avenue. This workshop, taking place on April 21, 2024, will introduce participants to various bookmaking techniques, including simple cut and folds, hand-stitched bindings, and hard-back covers. Led by Zoe, an experienced art tutor, attendees will create four handmade books like the 'Hot Dog' fold and the Accordion fold. The workshop is ideal for beginners looking to explore bookmaking. Participants will learn to use basic bookmaking tools safely, receive guidance on creating different types of books, and gain insight into enhancing their projects. The venue offers ample on-street parking and is conveniently located near Ben Rhydding and Ilkley train stations for those using public transportation. The ticket price for this workshop is £54.88, which includes all necessary materials. For any dietary requirements or inquiries, please contact hello@shortandfew.co.uk. More details and future workshop schedules can be found on Short & Few's website.

Book Launch: The Day of the Labyrinth, with author Roger Haydon Mitchell. | Cardigan Community Centre
Experience a captivating journey back to the fourth century CE with the launch of "Day of the Labyrinth," a novel by Roger Haydon Mitchell. Delve into a time where being a Christian meant rebellion against empire, violence, and personal gain - a stark departure from modern perceptions. Mitchell expertly weaves together historical facts and fantasy, exploring Christianity's roots to address timeless social and political dilemmas. Can love and hierarchy coexist? Is it possible to create a new world within the confines of the old? Discover the righteous path as Dr. Timothy Stacey from Urban Futures Studio, Utrecht University, provides profound insights. Join author Roger Haydon Mitchell at Cardigan Community Centre in Burley for this enlightening event on April 24, 2024. Admission is free, offering a unique opportunity to engage with the past while reflecting on the present. Don't miss the chance to be part of this thought-provoking exploration of ancient beliefs and their relevance in today's world.

Orchestral Wind Ensemble | All Saints' Parish Church, Ilkley
Don't miss the exclusive opportunity to experience a captivating evening of Orchestral Wind music at the Orchestral Wind Ensemble event in Ilkley. The talented wind section of the Ilkley Chamber Orchestra will delight the audience with renowned wind ensemble classics at the prestigious All Saints' Parish Church in Ilkley. The program features a stellar lineup including Gounod's "Petite Symphonie," Mozart's "Serenade for Wind in E flat," and Dvorak's "Wind Serenade in D minor." Immerse yourself in the enchanting melodies in the serene ambiance of the church on April 27, 2024. Tickets for this extraordinary musical event range from £6.13 to £13.70. Mark your calendars for a night of exceptional orchestral wind ensemble performances in the heart of Ilkley.

Botanical Sun Prints (Cyanotypes) | Short & Few Creative Workshops
Join Short & Few Creative Workshops in Ilkley for the Botanical Sun Prints (Cyanotypes) event. This workshop offers a unique opportunity to explore the fascinating process of cyanotypes, a cameraless form of photography that uses the sun to create beautiful blue and white prints.
During the workshop, participants will create their own cyanotypes using botanical leaves and flowers. The prints will be made outdoors, taking advantage of the sunlight to capture the intricate details of nature. All materials will be provided, and participants have the option to purchase cyanotype kits to continue the process at home.
The event will be held at Short & Few's garden in Ilkley, a serene location where seasonal blooms will be available for sampling. Participants are also welcome to bring their own cuttings. The workshop will be facilitated by Zoe, a qualified and experienced art tutor with a background in graphic design and typography.
No minimum ability is expected, making this workshop suitable for anyone with an interest in the arts, printing, and nature. Refreshments will be provided, and dietary requirements can be accommodated upon request.
Please note that the workshop space is not wheelchair accessible, and anyone under 18 must be accompanied by an adult. In case of inclement weather, the workshop will be conducted indoors using a lightbox.
Join Short & Few Creative Workshops for a truly magical experience with cyanotypes. For more information and to book your place, contact Short & Few Creative Workshops at hello@shortandfew.co.uk. Don't miss out on this opportunity to explore the art of botanical sun prints!

Jo Enright of Life's Too Short, Trollied and Phoenix Nights + Lovdev Baparga and Eric Powers Mwanza | The Hollygarth Club
In the vibrant town of Ilkley, a captivating arts event is set to take place featuring the talented comedians Jo Enright of Life's Too Short, Trollied, and Phoenix Nights, alongside Lovdev Baparga and Eric Powers Mwanza. This spectacular evening will unfold at The Hollygarth Club on Leeds Road on May 12, 2024. The event promises an entertaining blend of humor and wit, drawing inspiration from these renowned artists' illustrious careers. Attendees can expect an unforgettable experience filled with laughter and joy. Ticket prices for this extraordinary event range from £8.83 to £16.96, making it accessible to all comedy enthusiasts. Don't miss this unique opportunity to witness these comedy legends in action. Get ready to be amused and delighted as Jo Enright, Lovdev Baparga, and Eric Powers Mwanza grace the stage with their comedic brilliance. Mark your calendars and secure your tickets for a night full of laughter and entertainment.

Fused glass flower panel workshop | Mayfield Avenue, Ilkley LS29 8LF, UK
The Fused Glass Flower Panel Workshop offers a fantastic opportunity for individuals to attend a hands-on event where they can unleash their artistic side and learn the art of glass fusion. Hosted at Short & Few Creative Workshops in Ilkley, this workshop provides a unique experience for participants to create their very own fused glass flower panel.
Led by experienced glass fuser Claire Myers, attendees will be guided through the process of selecting colorful glass pieces and arranging them to create a stunning panel. No prior experience is required for this 1.5-hour workshop, where participants will learn how to apply various elements, such as frit, stringers, dots, and murine, to bullseye glass. The end result will be a charming and unique piece measuring 10x10cm.
Priced at £40 per person, the workshop fee includes all materials and refreshments. Additionally, a beautiful wooden stand will be provided to display the finished fused glass piece. Please note that this event is limited to a maximum of 6 people per workshop and is only available for individuals aged 18 and above.
After the workshop, participants' creations will be taken away to be fired and then posted to them approximately one week later. For those interested in booking both workshops, there is an opportunity to save £5. To secure a spot or inquire further, please contact the organizer directly. Don't miss this chance to join the Fused Glass Flower Panel Workshop and explore your creativity in a serene and supportive environment.

Fused glass hot air balloon workshop | Mayfield Avenue, Ilkley LS29 8LF, UK
Discover an amazing opportunity to take part in a highly anticipated fused glass workshop in Ilkley. Immerse yourself in the world of creativity and join us at the Short & Few Creative Workshops for an unforgettable experience. This workshop is specifically designed for individuals who are eager to unleash their artistic side and learn the intricate art of glass fusion.
Led by the renowned glass fuser, Claire Myers, this hands-on event will guide you through the entire process of creating two stunning hot air balloon hangings. No previous experience is required, making it the perfect opportunity for beginners to delve into the world of fused glass.
Throughout the workshop, you will experience the joy of selecting vibrant glass pieces and skillfully arranging and fusing them together to craft two unique hot air balloon hangings. The finished pieces will measure approximately 9x6cm and will be fired and adorned with a bail (hook) and a matching ribbon before being sent to your doorstep about a week later.
Priced at just £40 per person, this 1.5-hour workshop includes all necessary materials and refreshments to ensure a seamless and enjoyable experience. Please note that the workshop has a maximum capacity of 6 participants and is only open to individuals aged 18 and above.
Don't miss out on this extraordinary opportunity to delve into the captivating world of fused glass. Book your spot at the Fused Glass Hot Air Balloon Workshop now and save £5 when booking both workshops.

PERFORMANCE: Talking Stock - Le Grand Return | Ilkley Manor House
Experience the magic of PERFORMANCE: Talking Stock - Le Grand Return, a captivating arts event taking place at the historic Ilkley Manor House on May 24, 2024. Dive into a world of creativity and expression as talented performers take the stage to showcase their unique talents. With tickets priced at just £13.70, this event promises to be an unforgettable evening filled with mesmerizing performances that will leave you in awe. Located at Castle Yard, Ilkley, LS29 9DT, the venue provides the perfect backdrop for an evening of artistic excellence. Don't miss this opportunity to be part of something truly special. Book your tickets now and secure your spot at PERFORMANCE: Talking Stock - Le Grand Return. Join us for a night of entertainment that will leave you inspired and amazed.

Classical Music Concert including Rossini, Mozart and Beethoven | All Saints' Parish Church, Ilkley
Experience a night of classical musical excellence at the Classical Music Concert featuring the works of Rossini, Mozart, and Beethoven. Taking place on June 9, 2024, at All Saints' Parish Church in Ilkley, this event is perfect for both newcomers and seasoned attendees alike. The performance will commence with Rossini's enchanting Overture to the opera Semiramide, setting the stage for an unforgettable evening. The highlight of the concert will be the Mozart Sinfonia Concertante, showcasing talented wind soloists from the orchestra. The second half will enchant the audience with Beethoven's timeless and serene Pastoral Symphony. Immerse yourself in the brilliance of these classical masterpieces and create lasting memories of this extraordinary musical journey. Tickets for this exceptional event range from £9.38 to £16.96, offering a chance to witness the beauty of classical music at an affordable price. Don't miss this opportunity to revel in the magic of Rossini, Mozart, and Beethoven in the heart of Ilkley.

Serving across Borders: International Tennis Art | Ilkley Lawn Tennis & Squash Club
Discover how the elegant sport of lawn tennis has inspired artists worldwide at the event "Serving across Borders: International Tennis Art" hosted by Professor Ann Sumner. The lecture will delve into the artistic interpretations of the graceful movements and styles associated with the game throughout history. From capturing players' fluid motions on court to depicting the evolving fashions of the sport, artists have creatively integrated tennis into various genres of art. Renowned works by artists like John Lavery, Hurvin Anderson, and David Hockney will be explored, showcasing the diverse artistic responses to tennis. Taking place at the picturesque Ilkley Lawn Tennis & Squash Club in Ilkley on June 18, 2024, attendees can immerse themselves in this captivating discussion during the annual tennis tournament. Tickets range from £15 to £20, offering a glass of wine and strawberries and cream for an enriching experience. For more details on ticket prices and information, contact events@leedsartfund.co.uk. This event, generously supported by Hartleys Auctioneers and the Ilkley Lawn Tennis Club, promises to be a unique exploration of tennis in the world of art.
Experimental Cyanotypes | Short & Few Creative Workshops
Explore the captivating world of cyanotypes through an immersive one-day workshop on experimental cyanotypes at Short & Few Creative Workshops in Ilkley. Delve into the fascinating alternative photography process and uncover the magic of cyanotypes. In this workshop, participants will have the opportunity to experiment with ordinary household chemicals, manipulating the process to create extraordinary and abstract images. Using UV light, an iron compound chemical is transformed into stunning blue and white images. Discover the endless possibilities of cyanotypes and create a collection of unique experiments. If desired, these experiments can be bound into a beautiful book. All necessary materials will be provided, and cyanotype kits are available for purchase to continue the process at home. The workshop will be led by Zoe, a highly qualified and experienced art tutor. With a passion for process-driven arts and analog practices, Zoe believes in learning through doing and embracing mistakes as part of the artistic journey. This workshop is perfect for anyone interested in the arts, printing, and photography. No previous experience is required. The workshop will take place at Short & Few's studio cabin in Ilkley, LS29. Please note that the workshop space is not wheelchair accessible. Refreshments will be provided, and dietary requirements can be accommodated upon request. Secure your spot for this extraordinary workshop and unlock the artistic potential of cyanotypes. Contact Short & Few at hello@shortandfew.co.uk for any inquiries or to book your place. For more information about upcoming workshops, visit www.shortandfew.co.uk.

Mozart Great Mass in C Minor + choral works by Haydn & Mozart | St Margaret’s Church
Experience the breathtaking harmonies of the Mozart Great Mass in C Minor alongside captivating choral works by Haydn & Mozart at St Margaret’s Church in Ilkley on June 22, 2024. Immerse yourself in the celestial sounds of these iconic compositions in the serene ambiance of this historic venue. The event promises to be a musical journey like no other, transporting all who attend to a realm of sublime beauty and profound emotion. Don't miss this rare opportunity to witness the magic of these timeless masterpieces performed live. Secure your tickets now for £20.21 and treat yourself to an evening of classical music that will uplift your spirit and touch your soul. Join fellow music enthusiasts for an unforgettable night of cultural enrichment and artistic excellence. Let the music of Mozart and Haydn sweep you away on a wave of pure auditory bliss. Mark your calendars and prepare to be spellbound by the mesmerizing melodies of Mozart Great Mass in C Minor + choral works by Haydn & Mozart.

Comedian Scott Bennett plus Excellent Supporting Comedians at the Hollygarth Social Club, Ilkley | The Hollygarth Club
Don't miss the upcoming event "Comedian Scott Bennett plus Excellent Supporting Comedians" at the Hollygarth Social Club in Ilkley. Prepare for an evening of laughter as Scott Bennett and his talented companions grace the stage with hilarious stand-up comedy. The event, set to take place on June 30, 2024, promises a night filled with humor, camaraderie, and unforgettable moments. Scott Bennett, the headliner, has been praised by critics and fellow comedians for his exceptional wit and delivery. With ticket prices ranging from £8.83 to £16.96, this is an opportunity to witness a comedic talent that has been likened to industry greats like Peter Kay, Jason Manford, and John Bishop. Make sure to secure your spot at the Hollygarth Club for a night of side-splitting entertainment that is not to be missed.

Airedale Symphony Orchestra Summer concert | King’s Hall & Winter Gardens
Come and enjoy a magnificent evening of music with the Airedale Symphony Orchestra's Summer concert. Taking place on Sunday 30 June 2024 at 7.30pm, this unforgettable event will be held at the prestigious King's Hall in Ilkley. The programme will include a mesmerizing Festival Overture by Shostakovich, the enchanting Five Pieces for Orchestra by Webern, and the breathtaking Symphony no. 5 by Mahler. This is an opportunity to immerse yourself in the rich and vibrant sound of a local orchestra that never fails to captivate its audience.
Tickets for this extraordinary concert can be purchased online, at Ilkley Tourist Information, or at the door. Prices are as follows: adults £13, concessions £12, under 18s, full-time students, and unwaged individuals £6, and children under 11 can attend for free. Don't miss out on this sensational musical experience.
The Airedale Symphony Orchestra Summer concert promises to be an evening of pure wonder and delight. With its beautiful location at King's Hall and an exceptional programme filled with masterpieces, this is an event that music enthusiasts should not miss. Book your tickets now and be prepared to be transported to a world of harmonious bliss.

Transformation - Airedale Symphony Orchestra Summer concert | King’s Hall & Winter Gardens
Join the Airedale Symphony Orchestra for a mesmerizing evening of music at their summer concert, "Transformation". Taking place on Sunday, 30 June 2024 at 7.30pm, this exceptional performance will be held at the prestigious King's Hall in Ilkley. The programme for the evening includes an enchanting Festival Overture by Shostakovich, the Five Pieces for Orchestra by Webern, and Mahler's breathtaking Symphony no. 5.
Tickets for this event are available for purchase online, at Ilkley Tourist Information, and at the door. Prices are as follows: adults £13, concessions £12, under 18s, full-time students, and unwaged individuals £6, and children under 11 can attend for free. Don't miss this opportunity to immerse yourself in the captivating melodies of your local orchestra. Secure your tickets now for an unforgettable musical experience.

Classical Extravaganza | All Saints' Parish Church, Ilkley
Get ready to be swept off your feet at the upcoming Classical Extravaganza event in Ilkley. Taking place at the breathtaking All Saints' Parish Church on Church Street, this musical extravaganza is set to captivate audiences on July 20, 2024. With ticket prices ranging from £9.38 to £22.38, this event offers an affordable opportunity to experience the magic of classical music in a stunning setting. Whether you're a seasoned classical music enthusiast or a newcomer to the genre, this event promises to deliver a night to remember. So mark your calendars and secure your tickets for Classical Extravaganza, where you can immerse yourself in the beauty and grandeur of classical music. Don't miss out on this exceptional opportunity to indulge in a night of musical splendor at one of Ilkley's most iconic venues.

Bard in the Yard 2024 | Ilkley Manor House
Experience two abridged Shakespeare performances amidst the picturesque setting of Ilkley Manor House at Bard in the Yard 2024 this August. Witness a unique outdoor theatrical event as a talented troupe presents condensed versions of Shakespeare's masterpieces starting at 2pm with a break at 4:30pm. Richard III unfolds the tale of Richard Duke of Gloucester's ruthless ascension to the English throne, while The Tempest follows the enchanting story of Prospero, Miranda, Caliban, and Ariel on a magical island. Immerse yourself in the captivating performances on Saturday, August 24 at 7:30pm in the Wildman studio at Ilkley Playhouse, followed by shows on Sunday, August 25, and Monday, August 26, at 2pm in the Ilkley Manor House courtyard. Adult tickets are priced at £8, with student tickets available for £5. In case of inclement weather, the performances will seamlessly transition to the Playhouse. Don't miss this extraordinary cultural event in the heart of Ilkley.

Reading Places: Siting Art in a Rural Landscape | Wells Road
The Stanza Stones are six rocks carved with poems by Simon Armitage, inspired by, and sited in the upland Pennine watershed landscape where he grew up. The stones were created as part of the cultural Olympiad for the Ilkley Literature Festival in 2012. In this Olympic Year 12 years on, lead collaborator on the project, Landscape Architect Tom Lonsdale will guide a circular walk, describe the process of collaboration, choosing sites, the joys and challenges of implementing the project, and lead LIYHB's visit to Beck Stone, Puddle Stone, and the Poetry Seat. The walk will start and finish at Ilkley, on September 1st. Travel by train has been considered in the timing of this event. Meet at the car park, Wells Road at 10.50 to commence the walk at 11am. The full walk will take in Beck Stone the Poetry Seat, and Puddle Stone on Ilkley's upland landscape. Approximately 6 miles with some off road trails and uneven ground. *A shorter option is possible to visit Beck Stone and the Poetry Seat, then return to Ilkley, approximately 2 miles. Please prepare for the predicted weather, bring a packed lunch and water.
Information Source: Landscape Institute Yorkshire & Humber | eventbrite




